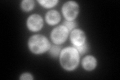
YBR143C
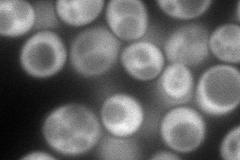
YBR143C
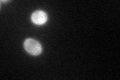
YBR143C

View description
Polypeptide release factor (eRF1) in translation termination; mutant form acts as a recessive omnipotent suppressor; methylated by Mtq2p-Trm112p in ternary complex eRF1-eRF3-GTP; mutation of methylation site confers resistance to zymocin
Localization:
Intensity:
Fold change:
Significance:
-
C’ GFP library in SD
cytosol311.39 -
N' NOP1pr-GFP in SD
cytosol140 -
N' TEF2pr-mCherry in SD

missing0 -
N' NATIVEpr-GFP in SD

missing0 -
N' TEF2pr-VC and Cyto-VN in SD

#N/A0 -
C’ GFP library in SD+DTT

cytosol311.971No -
C’ GFP library in SD+H2O2

cytosol282.670.9No -
C’ GFP library in Starvation Media
cytosol104.650.33Yes -
C’ GFP library on the background of Pup2-DaMP

cytosol -
C’ GFP library on the background of CCT mutant

cytosol333.6321.07139No
